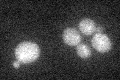
YFR008W
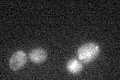
YFR008W

View description
Protein involved in recovery from cell cycle arrest in response to pheromone, in a Far1p-independent pathway; interacts with Far3p, Far8p, Far9p, Far10p, and Far11p
Localization:
Intensity:
Fold change:
Significance:
-
C’ GFP library in SD
cytosol25.96 -
N' NOP1pr-GFP in SD

cytosol63.9831 -
N' TEF2pr-mCherry in SD

cytosol59.9111 -
N' NATIVEpr-GFP in SD

below threshold19.126 -
N' TEF2pr-VC and Cyto-VN in SD

below threshold27.4296 -
C’ GFP library in SD+DTT

cytosol30.041.15No -
C’ GFP library in SD+H2O2
cytosol17.970.69No -
C’ GFP library in Starvation Media

cytosol22.590.87No -
C’ GFP library on the background of Pup2-DaMP

cytosol -
C’ GFP library on the background of CCT mutant

cytosol22.10150.851152No
